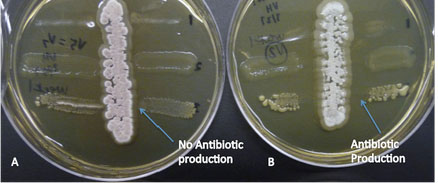

BISC209/F13: Lab9
LAB 9 Analyzing Your DNA Sequencing data and Finishing the Project
You will have a workshop to evaluate and analyze your 16S rRNA gene sequencing data
Complete Testing for Antibiotic Producers Among Your Cultured Isolates
Week 3
- Examine the plates you inoculated with known bacterial cultures last week and look for evidence of a zone of inhibition of growth near the antibiotic producer's midline streak
- Draw the results and evaluate whether or not there was evidence that an antibiotic was produced by your isolate and, if so, which of the known bacteria were sensitive to it and to what degree. If you found no inhibition of growth, does that mean that your isolate does not secrete an any antimicrobial compounds? Why or why not?
Finishing the project
After you have recorded all your isolate test results on a lab Google Doc, please discard all your cultures in the lab and in the storage cold room. You will receive 5 "clean-up points" if we do not find any evidence of your cultures or tests you will receive 5 points toward your lab grade. If we have to discard and clean-up later after you, you will not receive any of those points. The date clean up must be completed is Friday, Dec 6 at 10am; however, it would be better to take care of it now.
Assignment
Study for your Lab Practical (45points)
Information and Tips can be found at : Lab Practical.
Your final paper is due on Tues. Dec. 10 by 4pm (the last day of classes) for all students. You have all the data you need to start working on it. Instructions can be found at: Assignment: Final Paper
To Do:
Discard and clean up any remaining test materials and old cultures of your isolates.
Links to Labs
Lab 1
Lab 2
Lab 3
Lab 4
Lab 5
Lab 6
Lab 7
Lab 8
Lab 9
Lab 10